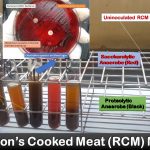
Anaerobic Bacteria Cultivation: Introduction, Principle, Procedure and Result Interpretation

Tag: procedure and result interpretation
Anaerobic Bacteria Cultivation: Introduction, Principle, Procedure and Result Interpretation
Introduction of Anaerobic Bacteria Cultivation Obligate anaerobes can not grow...
Introduction of Anaerobic Bacteria Cultivation Obligate anaerobes can not grow...
Acridine Orange Stain: Introduction, Principle, Procedure and Result Interpretation
 Introduction of Acridine orange Acridine orange is a fluorochrome stain...
Introduction of Acridine orange Acridine orange is a fluorochrome stain...
SARS-CoV-2 Genes detection using Real Time RT-PCR: Introduction, Principle, Procedure and Result Interpretation
 Introduction of SARS-CoV-2 genes detection SARS-CoV-2 genes detection using real-time...
Introduction of SARS-CoV-2 genes detection SARS-CoV-2 genes detection using real-time...
